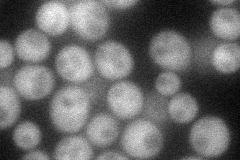
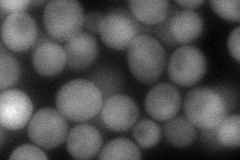
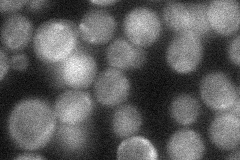
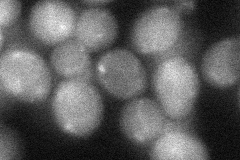
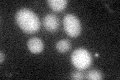

View description
Plasma membrane associated protein phosphatase involved in the general stress response; required along with binding partner Whi2p for full activation of STRE-mediated gene expression, possibly through dephosphorylation of Msn2p
Localization:
Intensity:
Fold change:
Significance:
-
C’ GFP library in SD

below threshold15 -
N' NOP1pr-GFP in SD
cytosol51.0383 -
N' TEF2pr-mCherry in SD
cytosol,punctate80.6975 -
N' NATIVEpr-GFP in SD
cytosol35.6197 -
N' TEF2pr-VC and Cyto-VN in SD
cytosol34.8934 -
C’ GFP library in SD+DTT
cytosol14.370.95No -
C’ GFP library in SD+H2O2

cytosol14.760.98No -
C’ GFP library in Starvation Media

cytosol17.611.17No -
C’ GFP library on the background of Pup2-DaMP

below threshold -
C’ GFP library on the background of CCT mutant

below threshold13.59160.905599No
